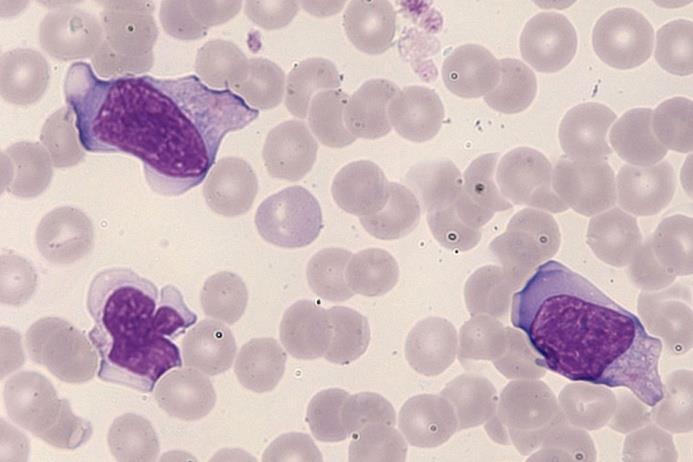
icsh外周血细胞形态特征的命名和分级标准化建议-配图:颗粒过多(中性

血细胞形态图

红细胞形态
图片尺寸538x638
正常血细胞形态-红细胞形态ppt
图片尺寸1080x810
临检检验科血细胞形态
图片尺寸1080x821
血细胞显微镜下形态
图片尺寸1004x654
卫健委临检中心2020年血细胞形态学检查室间质量评价及答案
图片尺寸1000x753
(一)红细胞
图片尺寸445x589
血液细胞形态学求助
图片尺寸765x1280
鸡血液各种细胞的形态
图片尺寸1500x1125
2018年细胞形态学培训考试
图片尺寸2578x1768
第18页 (共20页,当前第18页) 你可能喜欢 细胞图谱 血细胞形态学 血液
图片尺寸1080x810
红细胞形态检查hct红细胞膜红细胞聚集导致的仪器法网织红细胞计数
图片尺寸700x467
其它 周五血细胞美图 写美篇答案:多分叶核粒细胞 形态特征:胞体较大
图片尺寸1000x812
看图识细胞之"卫生部2017年第1次血细胞形态学质控"
图片尺寸640x465
其它 周五血细胞美图 写美篇答案:多核红细胞 形态特征:胞体较大,椭圆
图片尺寸1080x1080
超全汇总118张血细胞典型形态学图谱
图片尺寸660x495
血涂片细胞学检查:成熟红细胞形态大小不一,嗜多色性红细胞易见,见
图片尺寸660x496
地中海贫血血涂片异常红细胞形态.医学科学概念
图片尺寸700x496
血细胞形态图片
图片尺寸920x1302
看图识细胞之卫生部2017年第2次血细胞形态学质控
图片尺寸809x676
icsh外周血细胞形态特征的命名和分级标准化建议-配图:颗粒过多(中性
图片尺寸693x462